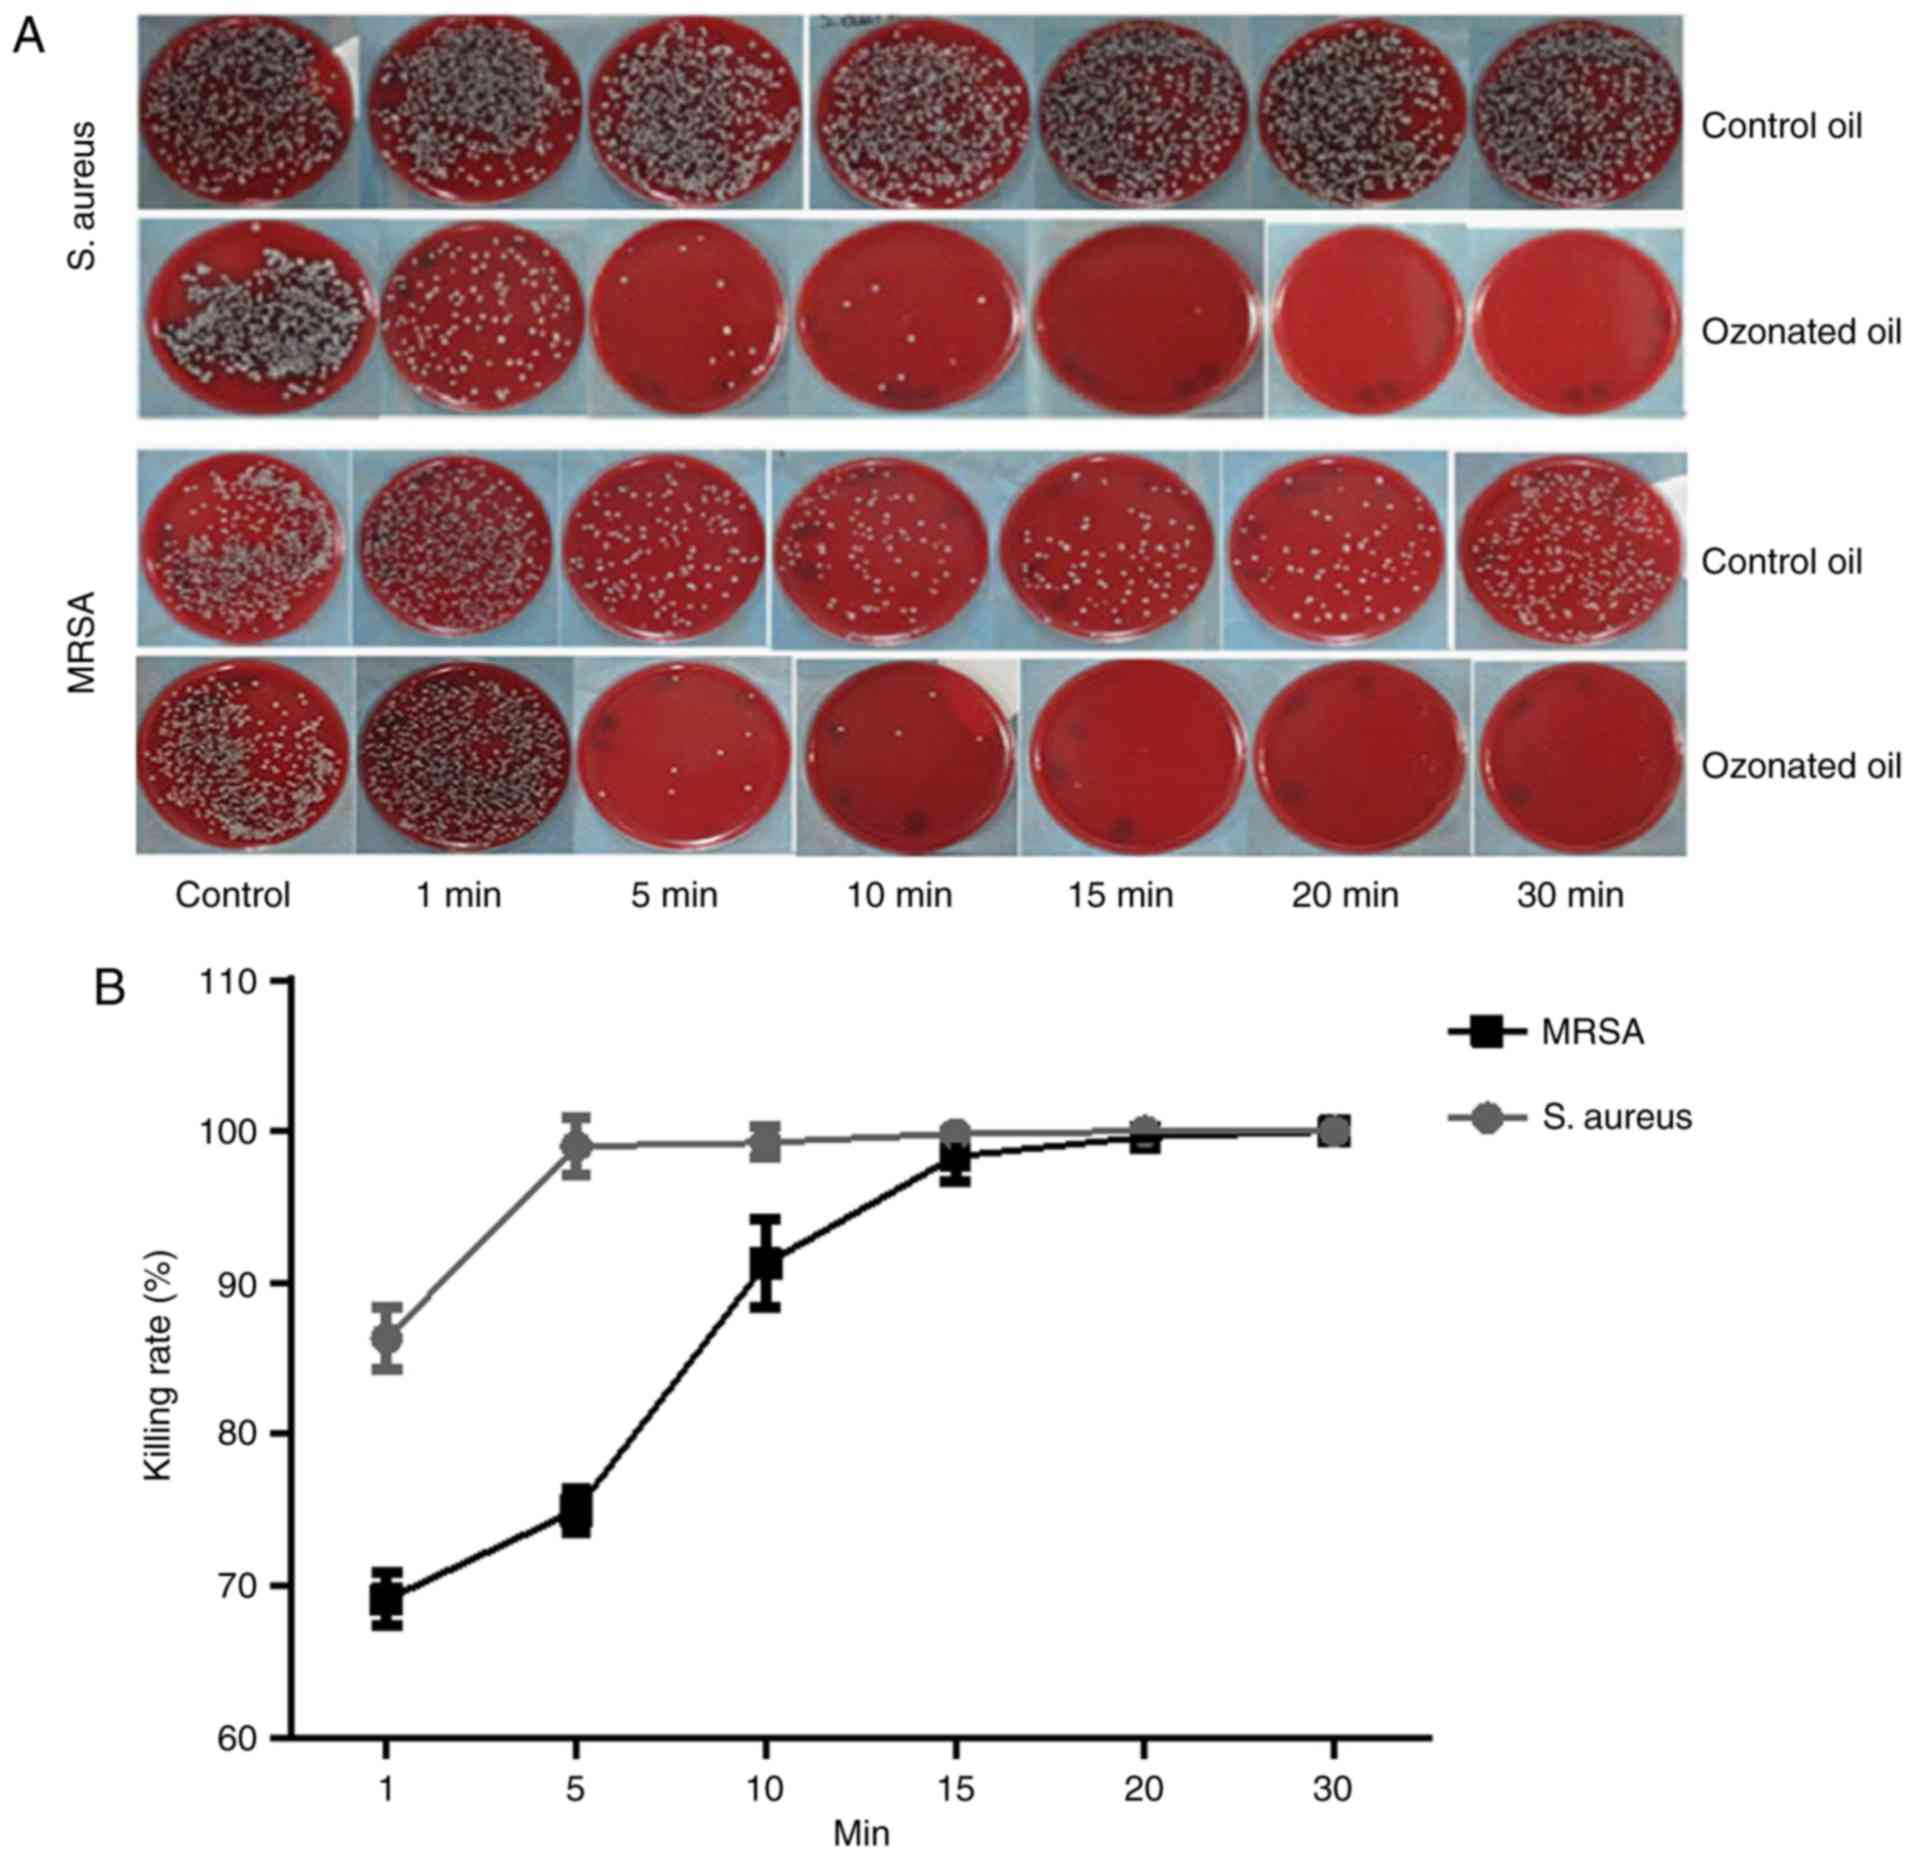

Introduction
Skin and soft tissue bacterial infections occur
frequently in the general population. They are characterized by
erythema, edema, and/or inflammation (1). and usually begin with an inflammatory
process in epidermis, dermis, or subcutaneous tissues, they can
spread to other parts of the body, leading to more serious symptoms
(2).
Antibiotic therapy is the option of choice for the
treatment. However, most of antibiotics could lose their potency
over time due to the antimicrobial resistance (3). Microbial resistance to
Staphylococcus aureus (S. aureus), especially
methicillin resistant Staphylococcus aureus (MRSA) and
vancomycin resistant-MRSA, is a grand challenge in clinical
practices globally (4,5).
Ozone is naturally occurring gaseous molecule of
triatomic allotrope of oxygen, formed recombination of oxygen atoms
and represented as O3 (6,7). The
original application of Ozone was to sterilize microorganisms in
drinking water (8). Now ozone has
been used for treatment of open wounds, Herpes Zoster and Herpes
Simplex (9,10), because of its anti-microorganism
effectiveness (11). Additionally,
ozone has other advantages like such as improving wound healing,
enhancing immune, no side effect, no-toxic, environmental friendly
and high efficacy (12). A few
studies have shown that ozone therapy is efficient in killing many
kinds of microorganisms, such as S. aureus,
Streptococci spp, Escherichia coli, Enterococcus
faecalis, and P. aeruginosa (13,14).
Studies also have shown that ozone therapy can
disinfect against S. aureus and MRSA strain in vitro
(14,15). In vivo studies have
suggested that ozone therapy is safe and exhibits antibacterial
effects for the treatment of peritonitis (16,17).
Ozone has shown its efficacy on healing MRSA skin infections when
combined with other drugs (18,19).
However, the effect of ozone therapy alone in the treatment of MRSA
skin infections is not to be determined.
This study aims to evaluate the microbicidal effects
of topical ozone therapy on S. aureus and MRSA and determine
its clinical efficacy on MRSA skin infections.
Materials and methods
Ethics approval and consent to
participate
This study was approved by the Ethics Committee of
The Third Xiangya Hospital, Central South University (Changsha,
China) and was carried out in accordance with the approved
guidelines. All patients provided written informed consent.
Material and equipment
The bacterial strains used in this study were S.
aureus (ATCC 6538) and MRSA (ATCC 43300). Bacterial culture
medium was purchased from Zhengzhou An Tu Biological Engineering
Co., Ltd. (Zhengzhou, China). Dimethylsulfoxide (DMSO) was from
Sigma-Aldrich (Merck KGaA, Darmstadt, Germany. Ozonated oil at the
peroxide value of 2,000 to 2,200 mmol-equiv/Kg [provided by Hunan
Health Care Technology Co., Ltd. (Hunan, China)] was obtained from
the chemical reaction between ozone and camellia oil because of its
high composition of unsaturated fatty acids. Ozonated water was
created by Ozone Water Generating Instrument (from Hunan Health
Care Technology Co., Ltd.) at the Dermatology Department of the
Third Xiangya Hospital.
Plating method
The bacterial strains were diluted with PBS to get
the concentration reaching at 108 CFU/ml.
For ozonated oil: The test oil suspension was
constituted by 400 µl ozonized oil mixes, 50 µl DMSO and 50 µl
microorganism suspension. Control oil suspension was constituted by
400 µl basal oil mixes 50 µl DMSO and 50 µl microorganism
suspension. Both groups were incubated in 37°C incubator for 1, 5,
10, 15, 20, and 30 min respectively. Then the suspension was plated
into Petri dishes and grew at 37°C for 24 h. Then the number of
colonies in each agar plate was calculated. The control suspension
constituted by 400 µl normal saline mixes 50 µl DMSO and 50 µl
microorganism suspension was used as control to calculate the
killing rate. Killing Rate (%)=(control colony number-oil colony
number)/control colony number).
For ozonated water: 1.0 ml of bacteria liquid was
mixed with 4.0 ml of ozonated water or PBS. 0.5 ml mixture was
added into 4.5 ml neutralizer (Phosphate buffer solution including
sodium thiosulfate) after oscillation for one minute. After that
the sample was planted into Petri dishes and cultured in an
incubator chamber at 37°C. The number of colonies in each agar
plate was calculated after growing for 24 h. Killing Rate
(%)=(control colony number-tested colony number)/control colony
number).
Kirby bauer method
The bacteria samples prepared above were dropped on
sterile cotton swabs. The surface was lightly and uniformly
inoculated by cotton swab on agar plate. Then the scrips
impregnated with ozonated oil or control oil were pasted into the
agar plate, followed by incubation at 37°C for 16–18 h. The
inhibitory ring test was performed. If the inhibition zone diameter
was bigger than 7 mm, it was considered effective; otherwise, it
was not.
Patients and ozone treatment
The Ethnic Committee of Third Xiangya Hospital
approved the study, and the informed consents of all the
participants were obtained. Two patients with skin MRSA infection
were recruited in this study. In addition to skin infections, no
other diseases were present in the two patients. The skin lesions
were washed or debrided by ozonated water in our therapy room once
a day, followed by application of ozonated oil twice per day at
home. Antibiotics and other drugs were not administrated during the
ozone therapy.
Bacteria culture, drug sensitive test
and PCR test of lesions
The lesions of patients were inoculated in the blood
plate, then cultured in an incubator chamber with 5% CO2
concentration at 35°C for 12 h. If there was colony formation of
microorganism, the microorganism colony was stained by Gram
staining. After confirming the gram-positive bacterial by the
microscope examination, three bacterial colonies were added into
physiological saline and were prepared with 0.5 turbidity ratio in
VITEK2 system (VITEK2 gram-positive identification card) by
electronic turbidimeter (DensiCHEK Plus, BioMérieux, Durham, NC,
USA). Then bacterial species and drug sensitivity results of the
samples were detected by Automatic Microorganisms Identification
System (VITEK2-compact). The drug sensitivity results were further
confirmed by VITEK2 AST-GP67 Test kit according to the
manufacturer's protocol. Following the preliminary result of MRSA
infection detected by Automatic Microorganisms Identification
System, the microorganism colony was further confirmed as MRSA
infection by the MRSA Quantitative Standards kit (no. Z-DD-0096-B;
Liferiver Bio-Tech, San Diego, CA, USA) according to the
manufacturer's protocol in CFX96™Red-Time System.
Statistical analysis
The data were analyzed in SPSS 19.0 software (SPSS,
Inc., Chicago, IL, USA). t-test was used to assess statistical
differences between two groups. P<0.05 was considered to
indicate a statistically significant difference.
Results
Killing rate of ozone on S. aureus and
MRSA
The killing rate of ozonated oil on S. aureus
was much higher than the control. Almost 100% S. aureus were
killed in 5 min. For MRSA, the killing rate of ozonated oil was
also much higher than the control oil. Almost 100% MRSA were killed
within 15 min (Fig. 1). The
killing rates over time between ozonated oil and control for S.
aureus and MRSA were presented in Tables I and II. The ozonated water (1 mg/l) can
sterilize 100% S. aureus and 100% MRSA in one minute
(Fig. 2).
 | Table I.Killing rate of ozonated oil on S.
aureus. |
Table I.
Killing rate of ozonated oil on S.
aureus.
|
| Killing rate |
|
|---|
|
|
|
|
|---|
| Time (min) | Control oil
(%) | Ozonated oil
(%) | P-value |
|---|
| 1 |
31.80±1.05 |
86.35±2.10 | <0.0001 |
| 5 |
40.81±8.27 |
99.01±1.90 | <0.0001 |
| 10 |
35.91±1.74 |
99.25±1.00 | <0.0001 |
| 15 |
36.04±3.37 |
99.84±0.24 | <0.0001 |
| 20 |
37.26±3.82 |
100±0.00 | <0.0001 |
| 30 |
37.16±1.44 |
100±0.00 | <0.0001 |
 | Table II.Killing rate of ozonated oil on
MRSA. |
Table II.
Killing rate of ozonated oil on
MRSA.
|
| Killing rate |
|
|---|
|
|
|
|
|---|
| Time (min) | Control oil
(%) | Ozonated oil
(%) | P-value |
|---|
| 1 |
44.70±0.97 |
69.09±1.73 |
0.0037 |
| 5 |
47.31±1.42 |
74.96±1.44 |
0.0004 |
| 10 |
42.99±5.69 |
91.25±2.91 |
0.0001 |
| 15 |
42.99±5.28 |
98.37±1.71 | <0.0001 |
| 20 |
41.65±6.7 |
99.65±0.09 | <0.0001 |
| 30 |
47.37±7.45 |
100±0.00 | <0.0001 |
Bacterial inhibitory: Inhibition zone
diameter
The inhibition zone diameters of ozonated oil for
S. aureus and MRSA were 17 and 13 mm respectively, which
were significantly much larger than the control (Fig. 3).
Practicing treatment
The first case
A 21-year-old male patient presented to the
Dermatology Department of our hospital complaining of a painful
abscess on his left calf muscle for approximately 20 days. Denied
any systemic diseases or health issues. Skin examination revealed
induration, bleeding and surrounding erythema in the left upper
Achilles tendon (Fig. 4A). The
overlying skin had become thin and felt fluctuant with spontaneous
pus secretion. Previous treatments included systemic antibiotics,
cleaning and dressing changes for more than 20 days without any
visible effect. Tests for diabetes and immune-suppression syndrome
were negative. Bacteria culture, drug sensitive test and PCR test
confirmed skin MRSA infection (Fig. 5A
and C). The strain was resistant to clindamycin, erythromycin,
cefoxitin, oxacillin, penicillin-G, piperacillin, and azithromycin
(Fig. 5A). After diagnosis of MRSA
infection, the patient voluntarily was put on topical application
of ozone therapy. Ozonated water was used to wash the lesion for 10
min immediately, followed by soak the lesion for 20 min after
debridement if necessary in our therapy room every day. The
application of topical ozonated oil twice per day was carried out
at home by the patient. Four days after treatment, the lesion was
cleaned to remove necrotic tissue and pus secretion (Fig. 4B). Affected areas were reduced by
more than 70% during the first month (Fig. 4C) and was almost healed by the end
of second month (Fig. 4D).
Bacteria culture test revealed that tissues from the lesion did not
develop bacteria one month after the topical ozone treatment.
The second case
An 8-year-old male patient presented to our
department complaining of a big blister on the dorsal aspect of the
left hand. Denied any systemic diseases and any treatment at the
moment. On skin examination, a 2×2 cm ulcerated lesion with yellow
crusts was seen with surrounding erythema and fluid exudation on
the dorsal aspect of the left hand. Laboratory tests confirmed MRSA
skin infection, resistant to clindamycin, cefotetan, erythromycin,
oxacillin, penicillin-G, and trimethoprim/sulfa-methoxazole
(Fig. 5B and D). A complete
healing from the lesion was achieved after 12 days of treatment
with a combination of ozonated water and ozonated oil using the
same remedy as we described in the first case (Fig. 6). Bacteria culture test revealed
that scales from the lesion did not develop bacteria 12 days after
the topical ozone treatment.
Discussion
In this study, we demonstrated that ozonated oil and
ozonated water have strong in vitro antibacterial effects
against S. aureus and MRSA. This is the first study to prove
that the topical application of ozone alone can be a powerful
treatment option for MRSA skin infections.
Data in this study have shown that ozonated oil can
sterilize up to 98% of S. aureus in 5 min and up to 98% of
MRSA in 15 min while ozonated water (1 mg/l) can sterilize 100% of
S. aureus and 100% of MRSA in one minute. This results
indicate that ozone therapy has very powerful anti-microbial
properties against gram positive microorganisms, which was
confirmed by the bacterial inhibitory experiment of ozonated oil.
Our results are consistent with reports regarding bacterial
elimination in S. aureus or MRSA by ozone therapy (20–23).
Notably ozone can sterilize both gram positive bacteria and gram
negative bacteria (24). Ozone is
an unstable molecule that rapidly decays to O2 and
releases a single oxygen atom. The single oxygen atom reacts with
the cell membrane of the bacteria, attacks the cellular components,
interrupts the normal cell activity and then destroys bacteria
(23,25).
Ozone therapy has been used for infectious diseases
such as conjunctivitis and keratitis (26), peritonitis (27), and surgical sepsis (28). In our clinical practice, topical
application of ozone therapy is very effective for healing MRSA
induced skin ulceration. The two cases got remarkable therapeutic
effects after ozone treatment alone. Besides the high efficiency
for sterilization, ozone therapy exhibits a potential effect in
wound healing. The possible mechanisms include: i) Increasing
oxygen levels, glucose and ATP transporter molecules in ischemic
tissues; ii) increasing the activity of bone marrow stem cells, so
as to promote angiogenesis and tissue regeneration; iii) the
upregulation of the expression of antioxidant enzymes in blood; iv)
Promoting the neuronal medium rise (29,30);
and v) Inducing growth factors (31). Ozone therapy was also reported to
reduce pain and swelling (32).
Patients in this study also presented significant decrease in pain
and swelling.
Diabetic foot ulcers are a challenging clinical
problem, characterized by neuropathy, peripheral arterial diseases,
foot deformities, and infection (33,34).
S. aureus was the most common pathogen identified in
Diabetic foot ulcers, representing 46% of culture-positive
patients. And 15% were classified as MRSA (35). Ozone application was not only to
kill S. aureus or MRSA, but also reported to significantly
reduce the lesion area in patient with diabetic foot (31,36,37).
Ozone also can improve glycemic control by controlling
hyperglycemia and insulin sensitivity and preventing oxidative
stress associated with diabetes mellitus and its complications
(38). Because of the low-cost,
ozone therapy can also reduce the medical bills for patients with
diabetes mellitus and its complications.
Ozonated water can keep the bactericidal effect for
approximately 30 min, while ozonated oil can maintain its
sterilization ability persistently (39–42).
This is why ozonated oil was applied to our patients after washing
with ozonated water to increase the effective time.
Although ozone therapy can kill microbes, improve
wound healing, reduce pain and swelling at minimal cost with almost
no side effect, it is contraindicated in several diseases such as
Blood Coagulation Failure, Bleeding Organs, Thrombocytopenia, Ozone
Alergia, Hemorrhagic or Apoplectic Stroke, Ozone Intolerance
(43).
In summary, ozone therapy is potential treatment for
S. aureus and MRSA skin infections with great efficacy, low
side effects, and low-cost.
Acknowledgements
This study was supported by Natural Science
Foundation of Hunan Province (no. 2015JJ6120), Scientific Research
Program of Department of Health of Hunan Province (no. B2015-034),
National Natural Science Foundation of China (no. 81703101),
Development and Reform Commission of Hunan Province [no. (2014)
658], Administration of Traditional Chinese Medicine of
HunanProvince (no. 201520), and the New Xiangya Talent Projects of
the Third Xiangya Hospital of Central South University (no.
JY201623). Special thanks to Dr Wenbin Tan and Dr Xiaoqi Wang for
the review.
Glossary
Abbreviations
Abbreviations:
|
S. aureus
|
Staphylococcus aureus
|
|
MRSA
|
methicillin resistant
Staphylococcus aureus
|
|
DMSO
|
Dimethylsulfoxide
|
References
|
1
|
Dréno B, Araviiskaia E, Berardesca E,
Gontijo G, Sanchez Viera M, Xiang LF, Martin R and Bieber T:
Microbiome in healthy skin, update for dermatologists. J Eur Acad
Dermatol Venereol. 30:2038–2047. 2016. View Article : Google Scholar : PubMed/NCBI
|
|
2
|
Diaz JH and Lopez FA: Skin, soft tissue
and systemic bacterial infections following aquatic injuries and
exposures. Am J Med Sci. 349:269–275. 2015. View Article : Google Scholar : PubMed/NCBI
|
|
3
|
Sully EK and Geller BL: Antisense
antimicrobial therapeutics. Curr Opin Microbiol. 33:47–55. 2016.
View Article : Google Scholar : PubMed/NCBI
|
|
4
|
Yang X, Zhang J, Yu S, Wu Q, Guo W, Huang
J and Cai S: Prevalence of Staphylococcus aureus and
methicillin-resistant Staphylococcus aureus in retail ready-to-eat
foods in China. Front Microbiol. 7:8162016. View Article : Google Scholar : PubMed/NCBI
|
|
5
|
Miller WR, Bayer AS and Arias CA:
Mechanism of action and resistance to daptomycin in Staphylococcus
aureus and enterococci. Cold Spring Harb Perspect Med. 6:pii:
a0269972016. View Article : Google Scholar
|
|
6
|
Greene AK, Few BK and Serafini JC: A
comparison of ozonation and chlorination for the disinfection of
stainless steel surfaces. J Dairy Sci. 76:3617–3620. 1993.
View Article : Google Scholar : PubMed/NCBI
|
|
7
|
Fiessinger F, Richard Y, Montiel A and
Musquere P: Advantages and disadvantages of chemical oxidation and
disinfection by ozone and chlorine dioxide. Sci Total Environ.
18:245–261. 1981. View Article : Google Scholar : PubMed/NCBI
|
|
8
|
Stalder K and Klosterkötter W: Studies on
the reappearing of a bacterial flora in drinking water after
ozonization (author's transl). Zentralbl Bakteriol Orig B.
161:474–481. 1976.(In German). PubMed/NCBI
|
|
9
|
Liu J, Zhang P, Tian J, Li L, Li J, Tian
JH and Yang K: Ozone therapy for treating foot ulcers in people
with diabetes. Cochrane Database Syst Rev: Cd008474. 2015.
View Article : Google Scholar
|
|
10
|
Bassi P, Sbrascini S, Mattassi R, D'Angelo
F and Franchina A: Ozone in the treatment of herpes zoster. Riv
Neurobiol. 28:328–333. 1982.(In Italian). PubMed/NCBI
|
|
11
|
Moureu S, Violleau F, Ali Haimoud-Lekhal D
and Calmon A: Ozonation of sunflower oils: Impact of experimental
conditions on the composition and the antibacterial activity of
ozonized oils. Chem Phys Lipids. 186:79–85. 2015. View Article : Google Scholar : PubMed/NCBI
|
|
12
|
Zhong J, Allen K, Rao X, Ying Z,
Braunstein Z, Kankanala SR, Xia C, Wang X, Bramble LA, Wagner JG,
et al: Repeated ozone exposure exacerbates insulin resistance and
activates innate immune response in genetically susceptible mice.
Inhal Toxicol. 28:383–392. 2016. View Article : Google Scholar : PubMed/NCBI
|
|
13
|
Farac RV, Pizzolitto AC, Tanomaru JM,
Morgental RD, Lima RK and Bonetti-Filho I: Ex-vivo effect of
intracanal medications based on ozone and calcium hydroxide in root
canals contaminated with Enterococcus faecalis. Braz Dent J.
24:103–106. 2013. View Article : Google Scholar : PubMed/NCBI
|
|
14
|
Heß S and Gallert C: Sensitivity of
antibiotic resistant and antibiotic susceptible Escherichia coli,
Enterococcus and Staphylococcus strains against ozone. J Water
Health. 13:1020–1028. 2015. View Article : Google Scholar : PubMed/NCBI
|
|
15
|
Sharma M and Hudson JB: Ozone gas is an
effective and practical antibacterial agent. Am J Infect Control.
36:559–563. 2008. View Article : Google Scholar : PubMed/NCBI
|
|
16
|
Gadzhiev ND, Nasirov Mla, Sushkov SV and
Klimova EM: Effect of combined and local cytokine- and ozone
therapy on the indices of lipid peroxidation, endogenous
intoxication and ferroproteins in diffuse peritonitis. Vestn Khir
Im I I Grek. 173:38–41. 2014.(In Russian). PubMed/NCBI
|
|
17
|
Kolesova OE, Vasil'ev IT, Volkhovskaia NB,
Mumladze RB, Tkachenko SB and Savina GD: Correction of the
antioxidative system during ozone therapy in peritonitis. Vestn
Ross Akad Med Nauk. 34–39. 2010.(In Russian). PubMed/NCBI
|
|
18
|
Tamai M, Matsushita S, Miyanohara H, Imuta
N, Ikeda R, Kawai K, Nishi J, Sakamoto A, Shigihara T and Kanekura
T: Antimicrobial effect of an ultrasonic levitation washer
disinfector with silver electrolysis and ozone oxidation on
methicillin-resistant Staphylococcus aureus. J Dermatol.
40:1020–1026. 2013. View Article : Google Scholar : PubMed/NCBI
|
|
19
|
Solovăstru LG, Stîncanu A, De Ascentii A,
Capparé G, Mattana P and Vâţă D: Randomized, controlled study of
innovative spray formulation containing ozonated oil and
α-bisabolol in the topical treatment of chronic venous leg ulcers.
Adv Skin Wound Care. 28:406–409. 2015. View Article : Google Scholar : PubMed/NCBI
|
|
20
|
Gulmen S, Kurtoglu T, Meteoglu I, Kaya S
and Okutan H: Ozone therapy as an adjunct to vancomycin enhances
bacterial elimination in methicillin resistant Staphylococcus
aureus mediastinitis. J Surg Res. 185:64–69. 2013. View Article : Google Scholar : PubMed/NCBI
|
|
21
|
Al-Saadi H, Potapova I, Rochford ET,
Moriarty TF and Messmer P: Ozonated saline shows activity against
planktonic and biofilm growing Staphylococcus aureus in vitro: A
potential irrigant for infected wounds. Int Wound J. 13:936–942.
2016. View Article : Google Scholar : PubMed/NCBI
|
|
22
|
Wilczyńska-Borawska M, Leszczyńska K,
Nowosielski C and Stokowska W: Ozone in dentistry: Microbiological
effects of gas action depending on the method and the time of
application using the ozonytron device. Experimental study. Ann
Acad Med Stetin. 57:99–103. 2011.PubMed/NCBI
|
|
23
|
Yamayoshi T and Tatsumi N: Microbicidal
effects of ozone solution on methicillin-resistant Staphylococcus
aureus. Drugs Exp Clin Res. 19:59–64. 1993.PubMed/NCBI
|
|
24
|
Almaz ME and Sönmez IŞ: Ozone therapy in
the management and prevention of caries. J Formos Med Assoc.
114:3–11. 2015. View Article : Google Scholar : PubMed/NCBI
|
|
25
|
Komanapalli IR and Lau BH: Inactivation of
bacteriophage lambda, Escherichia coli, and Candida albicans by
ozone. Appl Microbiol Biotechnol. 49:766–769. 1998. View Article : Google Scholar : PubMed/NCBI
|
|
26
|
Gierek-Lapińska A, Antoszewski Z, Myga B
and Skowron J: Preliminary report on using therapeutic ozone in
infectious conjunctivitis and keratitis and in corneal
degeneration. Klin Oczna. 94:137–138. 1992.(In Polish). PubMed/NCBI
|
|
27
|
Erginel B, Erginel T, Aksoy B and Dokucu
AI: Effect of Ozone Therapy (OT) on healing of colonic anastomosis
in a rat model of peritonitis. Balkan Med J. 31:249–253. 2014.
View Article : Google Scholar : PubMed/NCBI
|
|
28
|
Parkhisenko IuA and Glukhov AA: Use of
ozone therapy and hydro-pressure technologies in complex intensive
therapy of surgical sepsis. Khirurgiia (Mosk). 55–58. 2001.(In
Russian). PubMed/NCBI
|
|
29
|
Verrazzo G, Coppola L, Luongo C,
Sammartino A, Giunta R, Grassia A, Ragone R and Tirelli A:
Hyperbaric oxygen, oxygen-ozone therapy, and rheologic parameters
of blood in patients with peripheral occlusive arterial disease.
Undersea Hyperb Med. 22:17–22. 1995.PubMed/NCBI
|
|
30
|
Bocci VA: Scientific and medical aspects
of ozone therapy. State of the art. Arch Med Res. 37:425–435. 2006.
View Article : Google Scholar : PubMed/NCBI
|
|
31
|
Zhang J, Guan M, Xie C, Luo X, Zhang Q and
Xue Y: Increased growth factors play a role in wound healing
promoted by noninvasive oxygen-ozone therapy in diabetic patients
with foot ulcers. Oxid Med Cell Longev. 2014:2734752014. View Article : Google Scholar : PubMed/NCBI
|
|
32
|
Kazancioglu HO, Kurklu E and Ezirganli S:
Effects of ozone therapy on pain, swelling, and trismus following
third molar surgery. Int J Oral Maxillofac Surg. 43:644–648. 2014.
View Article : Google Scholar : PubMed/NCBI
|
|
33
|
Noor S, Khan RU and Ahmad J: Understanding
diabetic foot infection and its management. Diabetes Metab Syndr.
11:149–156. 2017. View Article : Google Scholar : PubMed/NCBI
|
|
34
|
Kateel R, Adhikari P, Augustine AJ and
Ullal S: Topical honey for the treatment of diabetic foot ulcer: A
systematic review. Complement Ther Clin Pract. 24:130–133. 2016.
View Article : Google Scholar : PubMed/NCBI
|
|
35
|
Reveles KR, Duhon BM, Moore RJ, Hand EO
and Howell CK: Epidemiology of methicillin-resistant Staphylococcus
aureus diabetic foot infections in a large academic hospital:
Implications for antimicrobial stewardship. PLoS One.
11:e01616582016. View Article : Google Scholar : PubMed/NCBI
|
|
36
|
Gazin IK: Pathophysiological aspects of
endotoxicosis complicated with purulent infection of the foot and
correction of endotoxicosis with conventional treatment and with
application of ozonized physiological solution in patients
suffering from diabetes mellitus. Patol Fiziol Eksp Ter. 23–25.
2008.(In Russian). PubMed/NCBI
|
|
37
|
Martínez-Sánchez G, Al-Dalain SM, Menéndez
S, Re L, Giuliani A, Candelario-Jalil E, Alvarez H,
Fernández-Montequín JI and León OS: Therapeutic efficacy of ozone
in patients with diabetic foot. Eur J Pharmacol. 523:151–161. 2005.
View Article : Google Scholar : PubMed/NCBI
|
|
38
|
Al-Dalain SM, Martínez G, Candelario-Jalil
E, Menéndez S, Re L, Giuliani A and León OS: Ozone treatment
reduces markers of oxidative and endothelial damage in an
experimental diabetes model in rats. Pharmacol Res. 44:391–396.
2001. View Article : Google Scholar : PubMed/NCBI
|
|
39
|
Bialoszewski D, Pietruczuk-Padzik A,
Kalicinska A, Bocian E, Czajkowska M, Bukowska B and Tyski S:
Activity of ozonated water and ozone against Staphylococcus aureus
and Pseudomonas aeruginosa biofilms. Med Sci Monit. 17:BR339–BR344.
2011. View Article : Google Scholar : PubMed/NCBI
|
|
40
|
Burke FJ: Ozone and caries: A review of
the literature. Dent Update. 39:271–272, 275–278. 2012. View Article : Google Scholar : PubMed/NCBI
|
|
41
|
Valacchi G, Zanardi I, Lim Y, Belmonte G,
Miracco C, Sticozzi C, Bocci V and Travagli V: Ozonated oils as
functional dermatological matrices: Effects on the wound healing
process using SKH1 mice. Int J Pharm. 458:65–73. 2013. View Article : Google Scholar : PubMed/NCBI
|
|
42
|
Pai SA, Gagangras SA, Kulkarni SS and
Majumdar AS: Potential of ozonated sesame oil to augment wound
healing in rats. Indian J Pharm Sci. 76:87–92. 2014.PubMed/NCBI
|
|
43
|
Zhang YB, Xiang YP, Huang JH, Gao L, Chen
M, Kathy W, Li M, Chen J, Yang S and Lu J: Combined ozone
hydrotherapy for atopic dermatitis: Evaluation of efficacy and
detection of interleukin-4 and nerve growth factor levels in
peripheral blood from patients before and after treatment. Chin J
Dermatol. 49:736–738. 2016.(In Chinese).
|